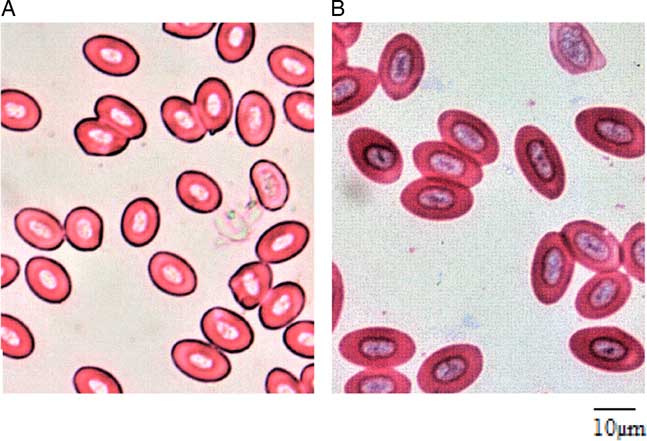
Figure 3

Introduction
Triploidy induction in fish is not a new concept as it has been successfully demonstrated in several aquaculture species (Felip et al., Reference Felip, Zanuy, Carrillo and Piferrer2001; Nell, Reference Nell2002; Tiwary et al., Reference Tiwary, Kirubagaran and Ray2004; Maxime, Reference Maxime2008, Piferrer et al., Reference Piferrer, Beaumont, Falguiere, Flajshans, Haffray and Colombo2009). The popularity of this method over other chromosome manipulation techniques is largely due to the ease of producing sterile aquaculture progenies or progenies with reduced sexual functionality (Allen & Stanley, Reference Allen and Stanley1978; Brown & Roberts, Reference Brown and Roberts1982; Neal, Reference Neal2003). Historically, scientific references on triploidization date back to the 1940s (Makino & Ozima, Reference Makino and Ozima1943; Svardson, Reference Svardson1945). Since then, many triploid aquaculture species have been commercially exploited. Hence, improved performance characteristics such as growth, meat production (Piferrer et al., Reference Piferrer, Beaumont, Falguiere, Flajshans, Haffray and Colombo2009; Berrill et al., Reference Berrill, MacIntyre, Noble, Kankainen and Turnbull2012; Fraser et al., Reference Fraser, Fjelldal, Hansen and Mayer2012) and by extension economic benefit and effective large-scale production of sterile fifishes have been widely exploited in commercial triploid fishes (Dunham, Reference Dunham2004; Maxime, Reference Maxime2008).
In addition, mass production of triploid fishes can be used to minimize genetic and ecological disorder that might result from interactions between wild and cultured fifishes (Cotter et al., Reference Cotter, O’Donovan, O’Maoileidigh, Rogan, Roche and Wilkins2000). Triploid fishes are therefore not considered to be ‘genetically modified organisms’ (Piferrer et al., Reference Piferrer, Cal, Álvarez-Blázquez, Sánchez and Martinez2000; Maxime, Reference Maxime2008). Moreover, triploidy also occurs naturally in the wild (Thorgaard, Reference Thorgaard1983). The occurrence of triploidy in the wild is largely because of the occasional failure of the extrusion of the second polar body in fertilized eggs (Thorgaard & Gall, Reference Thorgaard and Gall1979) due to environmental changes or hybrid stabilization (Legatt & Iwama, Reference Legatt and Iwama2003).
Under laboratory conditions, however, triploid fish are produced by inhibiting the release of this polar body II during the second stage of meiosis by shock treatment (Carman et al., Reference Carman, Oshiro and Takashima1991; Piferrer et al., Reference Piferrer, Beaumont, Falguiere, Flajshans, Haffray and Colombo2009). It is well known that shock-induced eggs for triploidization lead to reduced hatchability (Piferrer et al., Reference Piferrer, Cal, Álvarez-Blázquez, Sánchez and Martinez2000, Reference Piferrer, Cal, Gómez, Bouza and Martinez2003). The mystery behind this general observation in many previous studies could be unravelled by studying the embryogenetic development of the fish. However, this approach has not been given much attention in the past. Therefore, the effect of shock treatment on the timing of embryogenetic development is largely still unknown.
The non-pigmented and transparent nature of the Anabas testudineus (Bloch, 1792) egg, which facilitates easy observation, makes it one of the most important animal models for embryonic development studies in fish. In addition, this fish is a popular and highly priced aquaculture candidate in India, Malaysia, and several south-east Asian countries (Chaturvedi et al., Reference Chaturvedi, Ambulkar, Singh and Pandey2015). Hence, its performance and aquaculture value could be increased by inducing triploidization. The ‘climbing perch’ (as it is commonly called) are naturally domicile in the freshwaters, brackish waters and estuaries of several countries such as Pakistan, India, Nepal, Bangladesh, Sri Lanka, Southern China, Myanmar, Thailand, Singapore, Indonesia, Malaysia, Laos, Vietnam, Brunei and the Philippines (Talwar & Jhingran, Reference Talwar and Jhingran1991; Chondar, Reference Chondar1999; Jayaram, Reference Jayaram2010; Pal & Chaudhry, Reference Pal and Chaudhry2010). This study is specifically aimed at determining the spawning and embryonic development of diploid and heat-shocked triploid eggs of A. testudineus under controlled laboratory conditions.
Materials and Methods
Sexually mature broodstocks of A. testudineus obtained from wild catches were maintained separately in fibreglass tanks at the School of Fisheries and Aquaculture Science hatchery of the Universiti Malaysia Terengganu, in Malaysia. The broodstocks were acclimatized for 1 month before being used for this study. During the period of acclimation, they were fed commercial feed [45% crude protein (CP)] to satiation twice daily. Breeding and embryogenetic development reports for this study are the cumulative observation from three different breeding trials using two pairs of male and female brood fish (per trial). Both the male and females were injected with Ovaprim® hormone at a dose of 0.5 ml kg−1 of the body weight. They were separated into different rearing tanks (80 × 60 × 40 cm3) and allowed to swim freely for a latency period between 10 and 12 h. Eggs were then stripped from the females into a clean bowl by gently pressing the abdominal region of the fish. Similarly, gentle pressure was applied to the abdomen of the male broodstocks to extract the milt into a separate bowl. Fertilization was then done by mixing the eggs and milt as well as activation with water.
The fertilized eggs were quickly divided into two bowls as the treatment and the controlled group. The portions of eggs for the treatment group were ‘heat shocked’ at 41°C (for three min), to induce triploidization approximately 4 min after fertilization. However, the control group was not heat shocked. The control and treatment groups of eggs were immediately incubated in already prepared triplicates batches in a 100 litre fibreglass tank with continuous aeration. Water quality before and after heat shock (i.e. during the incubation) was monitored and kept optimum (temperature = 28.5 ± 0.4°C; pH = 7.13 ± 0.90; conductivity = 559 ± 3.88 µS cm −1; total dissolved solid = 254.0 ± 0.91 mg l −1; and dissolved oxygen = 5.06 ± 0.38 mg l −1). It is important to note, that due to the temperature sensitivity of studies such as these, digitally regulated heaters set at 28°C were used to maintain the temperature of the triplicated treatments baths throughout the incubation period/embryogenesis studies.
About 50 eggs were collected from each group (in Petri dishes) and observed under a Nikon dissecting microscope (Model number C-DSLS). A new batch of eggs was obtained for observation on 10-min basis through the early cleavages stages and on an hourly basis at the advanced stages of embryonic development. The different developmental stages were captured using a Sony camera (Cyber-shot 16.2MP Model number: DSC-TX10 50i) fitted to the microscope while the time of attainment of each stage was recorded as observed with a stopwatch. This monitoring was continued from the point of fertilization up to when the fry was hatched. It is also important to note that incubation in the triplicate fibreglass tank and embryonic observation under the microscope was done in a controlled environment (i.e. an enclosed room with an air conditioning system set at 28°C). Hence, it is believed that the environmental and water temperature during the study was substantially similar in all treatments as well as in all the experiments in the study (also confirmed with the mean water quality observed in the study).
Fertilization rate in this study was determined when embryogenesis was at the 2-cell or 16-cell stage following the method proposed by Okomoda et al. (Reference Okomoda, Koh and Shahreza2018). Hence, upon discriminating the ‘fertilized’ and ‘hydrated’ eggs (by observing actively dividing animal pole), the fertilization rate was estimated as shown in the equation below;
Hatchability percentage in this study was also determined using the equation below
Descriptive statistics for breeding parameters were performed using Minitab 14® computer software followed by Student’s t-test. Also, the status of triploidization was affirmed by observing the erythrocyte morphology of 2-month-old juveniles (mean weight = 5.6 ± 0.22 g) following the recommendation of numerous researchers (e.g. Karami et al., Reference Karami, Christianus, Ishak, Courtenay, Syed, Noor Azlina and Noorshinah2010; Pradeep et al., Reference Pradeep, Srijaya, Jose, Papini, Hassan and Chatterji2011; Normala et al., Reference Normala, Mohd, Abol, Nur, Khor and Shahreza2016).
Results and Discussion
The fertilization percentages of the two groups of eggs were similar (~90%) in this study (Fig. 1). This result was not surprising as the treatments were from similar breeding stocks and the heat shock was applied only after fertilization was carried out. The early cleavage stages of the developing embryos for both diploids and triploids (Fig. 2 and Table 1) were mainly mitotic discoidal meroblastic divisions characterized by an incomplete cleavage which exclusively occurred in the animal pole (Buzollo et al., Reference Buzollo, Verıssimo-Silveira, Oliveira-Almeida, Alexandre, Okuda and Ninhaus-Silveira2011; Olaniyi and Omitogun, Reference Olaniyi and Omitogun2013). This is similar to previous observations in many different species, resulting in blastomeres of relatively equal sizes (Kimmel et al., Reference Kimmel, Ballard, Kimmel, Ullmann and Schilling1995; Aluko, Reference Aluko1995; Olufeagba et al. Reference Olufeagba, Aluko, Omotosho, Oyewole and Raji1999, Reference Olufeagba, Okomoda and Shaibu2016 Arockiaraj et al. Reference Arockiaraj, Haniffa, Seetharaman and Sing2003; Ninhaus-Silveira et al., Reference Ninhaus-Silveira, Foresti and Azevedo2006; da Rocha et al. Reference da Rocha, Sato, Rizzo and Bazzoli2009). Subsequently, embryonic cleavage occurred in latitudinal directions, resulting in tiny blastomeres often referred to as ‘mulberry’ or ‘half-berry’ or ‘ball’-like shapes (Honji, et al., Reference Honji, Tolussi, Mello, Caneppele and Moreira2012; Olaniyi & Omitogun, Reference Olaniyi and Omitogun2013). The relatively small sizes of these cells made them impossible to count. It is important to note that despite the similarities of the embryogenetic stages (i.e. beyond the 2-cell stage); the triploid eggs were quite slow to develop (15 min to 5 h late) when compared with the diploid eggs. It is believed that the three min heat shock applied approximately 4 min after fertilization for the triploidization process slowed down biological activities significantly. So, in addition to retention of the second polar body, embryonic development time was delayed to when the eggs hatched. This observation is at variance with the reports of Happe et al. (Reference Happe, Quillet and Chevassus1988) for rainbow trout Saho gairdneri, as here triploid eggs hatched earlier than their control diploid group.

Figure 1 Spawning performance of the eggs of diploid and heat shock-induced triploid Anabas testudineus.

Figure 2 Normal embryogenesis as observed in the diploid or triploid developing eggs of Anabas testudineus under laboratory conditions. (1) Blastodisc formation. (2) 2-cell stage. (3) 4-cell stage. (4) 8-cell stage. (5) 16-cell stage. (6) 32-cell stage. (7) 64-cell stage. (8) 128-cell stage. (9) Morula stage. (10) Early blastula stage. (11) Mid-blastula stage. (12) Late blastula stage. (13) Pre-early gastrula stage. (14) Early gastrula stage. (15) Mid-gastrula stage. (16) Late gastrula stage. (17) Early neurula; head formation. (18) Late neurula; optic bud formation. (19) Six somite; brain and optic vesicle formation. (20) Nine somite; appearance of heart analogue. (21) Twelve somite; heart formation. (22) Sixteen somite; start of heartbeat. (23) Eighteen to nineteen somite; onset of blood formation. (24) Hatchlings (Bar = 0.5 mm).
Table 1 Description of the embryogenesis of diploid and triploid developing eggs of Anabas testudineus under laboratory conditions (Temperature = 28.6 ± 1.1°C). Numbers are means hours:minutes

Aydın & Okumus (Reference Aydın and Okumus2017) had earlier described that abnormal cell cleavage in triploid black sea turbot (Psetta maxima) eggs was the main reason for low hatchability in their study. Other studies by Devauchelle et al. (Reference Devauchelle, Alexandre, Le Corre and Letty1988), Kjørsvik et al. (Reference Kjørsvik, Mangorjensen and Holmefjord1990, Reference Kjørsvik, Hoehne-Reitan and Reitan2003) and Pickova et al. (Reference Pickova, Dutta, Larsson and Kiessling1997) also demonstrated a positive correlation between high hatching rate and percentage of normal blastomere division. Contrary to these observations, abnormal cleavage was not observed on a large scale in this study and therefore it was not thought to be the main cause of the low hatchability observed (i.e. 50.04 versus 79.56% respectively for triploid and diploid eggs). However, mass mortality of eggs was recorded in the somite stages and was thought to be the most critical developmental stage in this study. Similar mass mortality has been reported previously by Okomoda et al. (Reference Okomoda, Koh, Hassan, Amornsakun and Shahreza2017) for progenies of ♀P. hypophthalmus × ♂C. gariepinus during the somite stages. Importantly, similar types of mortality were observed in the triploid eggs rather than in the diploid eggs. Therefore, while mortality in the study by Okomoda et al. (Reference Okomoda, Koh, Hassan, Amornsakun and Shahreza2017) could be explained by hybridization effects, the observations of the current study is more likely to be connected with the detrimental effect of the heat-shock process applied for triploidization.
Erythrocyte size variation between triploid and diploid eggs has been well established in many previous studies and has long been found pride of place as a simple index of discrimination. No matter the shape of the diploid erythrocytes (rounded or oval), triploids of the same age and size usually possess more than 1.5 times (and above) the erythrocyte major axis of their diploid counterparts (Lincoln & Scott Reference Lincoln and Scott1983; Varadaraj & Pandian Reference Varadaraj and Pandian1990; Koedprang & Na-Nakorn, Reference Koedprang and Na-Nakorn2000; Gao et al., Reference Gao, Wang, Abbas, Zhou, Yang, Diana, Wang, Li and Sun2007; Dorafshan et al., Reference Dorafshan, Kalbassi, Pourkazemi, Amiri and Karimi2008; Karami et al., Reference Karami, Christianus, Ishak, Courtenay, Syed, Noor Azlina and Noorshinah2010; Normala et al., Reference Normala, Mohd, Abol, Nur, Khor, Okomoda and Shahreza2017). Although detailed biometrics of the erythrocytes of both diploid and triploids were not reported in this current study, visual observation of both groups affirmed the suitability of erythrocyte morphology as a simpler index of discrimination between the diploid and triploid A. testudineus in line with the findings of many previous studies (Fig. 3). According to Benfey (Reference Benfey1999) and Normala et al. (Reference Normala, Mohd, Abol, Nur, Khor and Shahreza2016), the increased erythrocyte size of the triploids is a significant biological response resulting from an increment in one chromosome set.

Figure 3 Erythrocyte morphology of (a) diploid; and (b) triploid Anabas testudineus. (Bar = 10 µm).
Acknowledgements
The authors are indebted to the School of Fisheries and Aquaculture Science, Universiti Malaysia Terengganu, Malaysia in whose facility this research was conducted. We also acknowledge the help of the technical staffs of the Pusat Pengajian Sains Perikanan dan Akuakultur (PPSPA) hatchery department during experimental trials of this study.
Conflict of Interest
None